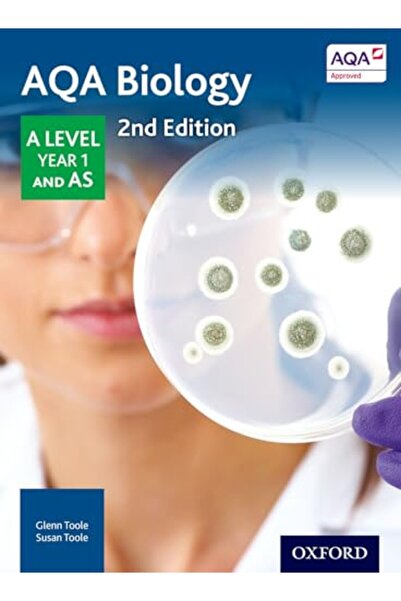
OXFORD UNIVERSITY PRESS علم الأحياء Aqa مستوى السنة الأولى وما بعدها

المساعدة والدعم
الفئات
جديد
النساء
الرجال
السوبرماركت والصحة
الأطفال
المنزل
الأحذية والحقائب
الرياضة والهواء الطلق
مستحضرات التجميل
لوازم السيارة وتحديث البيت
أجهزة كهربائية
الهوايات والكتب
المرأةملابسجديدنافساتينبلوزات وقمصانسويتشيرتات وهوديسجينزات وبنطلوناتبليزرات وجاكيتاتتنانيرشورتاتمجموعات من قطعتينجمبسوتاتمايوهات وملابس بحرلانجري وملابس منزليةملابس رياضيةمجموعة المقاسات الكبيرةضروريات الموضةإطلالات كاجوالفساتينفساتين بوديكونفساتين بقصة A-Lineفساتين فضفاضةفساتين كاجوالفساتين صيفيةفساتين حفلةفساتين سهراتقطع علويةجديدناتي-شيرتاتبلوزاتقمصانبادي سوتاتسويتشيرتات وهوديسبليزراتفيستاتبلوزات كم طويلبلوزات عارية الكتفينقمصانتونيكاتبلوزات فضفاضةبنطلونات وجينزاتجينزاتبنطلوناتليقنزبنطلونات رياضيةشورتاتتنانيرجينزات قصة ضيقةجينزات مام وبويفريندجينزات قصة فضفاضةجينزات خصر عالٍجينزات بساق واسعةجمبسوتات جينزبنطلونات كارغوبنطلونات رسميةأحذية وأكسسواراتأحذية رياضيةكعب منخفضملابس رياضيةليقنز رياضيةتي-شيرتات رياضيةحمالات صدر رياضيةفساتين للمحجباتأطقم من قطعتين للمحجباتقبعات وعباياتقمصان للمحجباتالحجابتنانير للمحجباتفساتين سهرة للمحجباتتونيكات الموضة المتواضعةبنطلونات للمحجباتالحجاب كيمونوأطقم رياضية للمحجباتبليزرات للمحجباتكارديغانات للمحجباتكنزات للمحجباتالماكياجالعناية بالبشرةالعناية بالشعرالحلاقة. إزالة الشعر بالشمعالعناية بالفمالنظافة الشخصيةالعناية بالمنزل والتنظيفرعاية الأم والطفلالصحةالحيوانات الأليفةالرجلملابسجديدناتي-شيرتاتقمصان بولوقمصانسويتشيرتات وهوديسبليزرات وجاكيتاتجينزاتبنطلوناتشورتات وبرمودامايوهات وملابس بحربنطلونات رياضيةأطقم رياضيةملابس رياضيةملابس داخليةملابس نومجواربضروريات الموضةأعمالقطع علويةجديدناتي-شيرتاتقمصان بولوقمصانسويتشيرتات وهوديستي-شيرتات رياضيةكنزات وكارديغاناتفيستاتجاكيتات جنيزبنطلونات وجينزاتجديدنابنطلوناتبنطلونات رياضيةشورتات وبرموداشورتات سباحةعرض كل الجينزاتجينزات قصة ضيقةجينزات قصة فضفاضةجينزات قصة عاديةأحذية وأكسسواراتعرض كل الأحذيةجديدنا من الأحذيةأحذية سنيكرزصنادل وأخفافكعب منخفضأبواتعرض كل الأكسسواراتجديدنا من الأكسسواراتحقائب وحقائب ظهرجواربنظارات شمسيةأحزمةملابس رياضيةمايوهات وملابس بحرسويتشيرتات وهوديسشورتاتأحذية رياضيةتي-شيرتات رياضيةفساتينأحذية رياضيةأطقم رياضيةأطقم بيجامةتي-شيرتاتأحذية كاجوالشورتاتبنطلوناتتنانيرليقنزمايوهاتأحذية رياضيةأطقم رياضيةملابس نومتي-شيرتاتأحذية كاجوالشورتاتبنطلوناتفساتينأحذية رياضيةأطقم رياضيةملابس حديثي الولادةقماش موسلينجمبسوتاتمجموعات الطفلملابس نومتي-شيرتاتأحذية كاجوالشورتاتبنطلوناتأحذية رياضيةأطقم رياضيةملابس نومملابس حديثي الولادةقماش موسلينجمبسوتاتمجموعات الطفلتي-شيرتاتأحذية كاجوالشورتاتبنطلوناتالأم والرضيع والطفلالتغذية والرضاعة الطبيعيةمرحاض حمام الطفلهدية الطفلشنط الأطفالمنتجات العناية بالأممناديل مبللةمنتجات العناية بالأطفالحفاضاتلُعَبالزلاجات الدوارة وألواح التزلج والسكوترلُعّب البناءألعاب تعليميةالألعاب التعليمية والخشبيةمجموعات ألعابدُمىألعاب قطيفةأدوات المائدة والمطبخأواني الطهيأدوات المائدةأدوات تنظيم المطبختحضير الشاي والقهوةتحضير الطعاممعدات الخبززجاجياتمجموعة القدح والقدحملاقط تقديم الطعامالمنسوجات المنزليةمجموعة أغطية السريرأغطية الأرائكمنسوجات المطبخمجموعة الأوراقأغطية سريرالوسائدمجموعة غطاءحماة المراتببطانياتمنسوجات غرفة الأطفاللحف وأغطيةمجموعة النومالحمامالمناشفمنظمات حمامأرواب حمامأطقم حمامأرواب حمام للأطفال والرضعسجادات حمامطبق صابونفرشاة مرحاضبيشتيمالسديكور المنزلالإنارةسجاد وبسط ومماسح أرجلمنظمو الخزاناتمرآةوسائد وأغطية وسائدطبق ووعاء للزينةطاولات قهوةرف المعاطفخزانة أحذيةمقعد الألعابفراش ووسادة فراشرف المطبخمكتب دراسةأرفف كتبثرياحامل شمعدانغطاء مصباحأحذية سنيكرزأحذية الجري والتدريبأحذية المشيأحذية كرة قدمأحذية كرة القدمأحذية كرة سلةأحذية الأنشطة الخارجيةأحذية تنسحقائب سفرحقائب كتفحقائب اليدحقائب ظهرشنط الأطفالحقائب السهرةحقيبة ماسنجرحقائب خصرحقائب رياضيةحقائب المحفظة والقابضالحقائب المدرسيةصناديق الغداءميولزصنادلأحذية بكعب عالٍأحذية السهرةأحذية بمقدمة مدببةأحذية بكعب إسفينأحذية باليريناأحذية رسميةأحذية بكعب مسطحأحذية لوفررياضة قماشيةحذاء أكسفوردالأساورقلائدأقراطخواتمساعات يدمحافظحاملات البطاقاتنظارات شمسيةأبواتأبوات بطول الركبةشالاتمسبحة الصلاةشباشب للمنزلأحذية مائيةأطقم رياضيةبنطلونات رياضيةقمصان رياضيةليقنز رياضيةشورتات رياضيةالرياضةالزلاجات الدوارة وألواح التزلج والسكوترحالة اللياقة البدنيةأكسسوارات رياضيةالرياضات المائيةمطرات ترمس وأكوابأحذية الأنشطة الخارجيةمعدات التخييمبليزرات رياضيةمعدات الصيد صيد السمكسترات رياضيةأكسسوارات الأنشطة الخارجيةبنطلونات رياضيةالإسعافات الأولية والسلامةأطقم خلاطاتماكينات قهوةكاوياتماكينة التوستخلاطات صغيرةغلايات ماءماكينات فرم وتقطيععصارات فاكهة وخضارخفاقاتماكينات شايماكينة صنع الوافلمحامص خبزماكينة صنع الزباديمكواة الشعرمجفف شعرمجعد الشعركمبيوتراتأجهزة التابلتشاشةأجهزة تخزين البياناتمكونات الكمبيوترأكسسوارات التابلتحقائب وحافظاتملحقات الكمبيوتر اللوحيمستلزمات الكابلاتطابعات وماسحات ضوئيةمشغلات الوسائطأكسسوارات التلفزيونكابلات HDMIساعة ذكيةتليفون محمولالغطاء والحالةسماعات الرأسشواحن سلكيةكابل الشحنملحقات الهاتفكونسولات الألعابألعابأكسسوارات الكونسولاتأحمر الشفاهمستحضرات الأساسظلال العيونكريمات BB وCCالكونسيلرأحمر خدودالغلوسالماسكاراحقائب الماكياجفُرَش الماكياجأقلام الشفاهكحلمساحيق الوجههايلايترمثبتات الحواجبكريمات الوجهواقيات الشمس للوجهسيروم البشرةغسول الوجهأقنعة الوجهمستحضرات التسمير الذاتيمرطبات الجسمزيوت العنايةواقيات الشمسبلاسم الشفاه وتقشيرهاكريمات اليدينديرمارولرمزيلات الماكياجسيروم العيونمنتجات الحلاقةأقنعة الشعرالعناية بالشعرفُرَش وأمشاط الشعرمقويات الشعرفيتامينات الشعرمعجون الأسنانرؤوس فُرَش الأسنانفُرَش أسنانالعطور والعناية الشخصيةضباب الجسممجموعات العطورمزيلات العرقلوازم الأعراس والحناءبالوناتأزياء تنكرية للحفلاتمناديل ضيافة للحفلاتزينة أعياد الميلادتيجان الحفلاتأكواب بلاستيكيةلوازم الحفلاتأطباق بلاستيكيةمصاصاتزينات كعكة عيد الميلادأقنعة الحفلاتملصقدفاترأجنداتأدوات الإشارة المرجعية للكتبألبومات صورمغلفاتألواح الكتابةألواح عرضمجموعة أوكيمجموعات الألعاب الأخرىطاولات زهرورق اللعبشطرنجكتاب تعليم اللغات الأجنبيةكتاب الأطفال باللغات الأجنبيةروايات اجنبيةقلممقلمة قلم رصاصالمواد الفنيةممحاةمجموعة الرسمحبل للحياكةخرزقماشخيط تطريزاطقم امربروديريضفيرة للزينةالمسرح والاستوديوقيثارة أكلالالآلات الإيقاعيةلغزملحقات شارة الاسمالشريط ومسدس الشريطحامل القلممادة التغليفبيني بنكأقلام تلوينملفصنابيرحوامل تثبيتالأبواب ومستلزماتهامعدات الأثاثمقابسأطقم المقابسالتثبيتمفاتيح الإضاءةتوصيلات كهرباءحبال على أنواعهاطقم مفتاح ومقبسغطاء لمقعد المرحاضأشرطة حماية للنوافذ والأبوابأقفالمصدّات الأبوابأكسسوارات داخلية للسيارةأكسسوارات خارجية للسيارةمنتجات العناية بالسياراتبطاريات سيارات وأكسسواراتهامنتجات ضبط السيارةمنتجات الشتاءأدوات الحدائق الصغيرةالشواية والشواءمعدات الريّإطار الشريطأجزاء كهربائيةغطاء رأسفرامل وقابضالأجزاء المتحركة والتوجيهالأجزاء الميكانيكيةفلترنظام الإشعالملابس للدراجات الناريةأكسسوارات الدراجات الناريةمعدات حماية للدراجات الناريةوجبات خفيفةقهوةشايمنتجات الفطورشاي عشبيالفاكهة المجففةراحة الحلقومقهوة تركيةفيتامينالكولاجينمسحوق البروتينزيت سمكحفاضاتبروبيوتيكالمكملات الغذائية الرياضيةالعناية بالفمالحلاقة. إزالة الشعر بالشمعالعناية بالشعرالنظافة الشخصيةمنتجات الاستحمامالعناية بالبشرةحفاضاتمناديل مبللةكريمات وزيوت الأطفالشامبو أطفالأدوات التنظيفمنتجات غسيل الملابسمنتجات ورقيةمواد المطبخ الاستهلاكيةمنتجات القططمنتجات الكلابسرير القططالعاب القططMustelaJohnson'sPampersViledaSleepyGillette VenusNiveaArgivitOptimum Nutrition